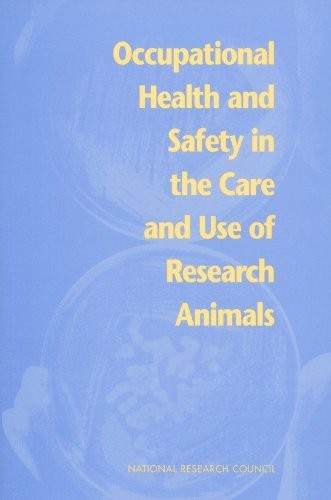

Occupational Health and Safety in the Care and Use of Research Animals
Occupational Health and Safety in the Care and Use of Research Animals
Regular price
Checking stock...
Regular price
Checking stock...
Summary
Useful as a companion to "Guide For the Care and Use of Laboratory Animals", this book identifies principles for building a program, and discusses the accountability of institutional leaders, managers, and employees for a program's success. It also provides a description of risks - physical and chemical hazards, allergens and zoonoses, and more.
The feel-good place to buy books
- Free US shipping over $15
- Buying preloved emits 41% less CO2 than new
- Millions of affordable books
- Give your books a new home - sell them back to us!
Occupational Health and Safety in the Care and Use of Research Animals by National Research Council
Much has been written about the care of research animals. Yet little guidance has appeared on protecting the health and safety of the people who care for or use these animals. This book, an implementation handbook and companion to Guide For the Care and Use of Laboratory Animals, identifies principles for building a program and discusses the accountability of institutional leaders, managers, and employees for a program's success. It provides a detailed description of risks—physical and chemical hazards, allergens and zoonoses, and hazards from experiments—which will serve as a continuing reference for the laboratory. The book offers specific recommendations for controlling risk through administrative procedures, facility design, engineering controls, and periodic evaluations. The volume focuses on the worker, with detailed discussions of work practices, the use of personal protective gear, and the development of an emergency response plan. This handbook will be invaluable to administrators, researchers, and employees in any animal research facility. It will also be of interest to personnel in zoos, animal shelters, and veterinary facilities. Table of Contents FRONT MATTER INTRODUCTION, OVERVIEW, AND RECOMMENDATIONS PROGRAM DESIGN AND MANAGEMENT PHYSICAL, CHEMICAL, AND PROTOCOL-RELATED HAZARDS ALLERGENS ZOONOSES PRINCIPAL ELEMENTS OF AN OCCUPATIONAL HEALTH AND SAFETY PROGRAM OCCUPATIONAL HEALTH-CARE SERVICES REFERENCES INDEX
Committee on Occupational Safety and Health in Research Animal Facilities, Institute of Laboratory Animal Resources, Commission on Life Sciences, National Research Council
| SKU | Unavailable |
| ISBN 13 | 9780309052993 |
| ISBN 10 | 0309052998 |
| Title | Occupational Health and Safety in the Care and Use of Research Animals |
| Author | National Research Council |
| Condition | Unavailable |
| Binding Type | Paperback |
| Publisher | National Academies Press |
| Year published | 1997-07-09 |
| Number of pages | 168 |
| Cover note | Book picture is for illustrative purposes only, actual binding, cover or edition may vary. |
| Note | Unavailable |